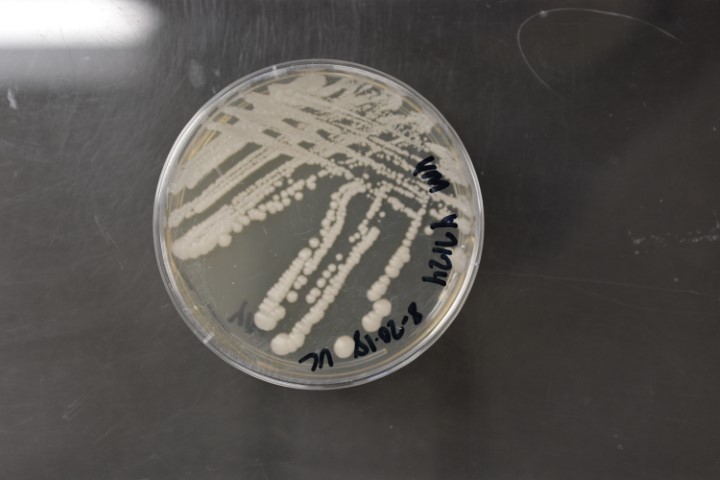

Scheffersomyces stipitis
NRRL Y-7124(Type Strain)
Accession numbers in other collections:ATCC 58376=BCC 47637=CBS 5773=CCRC 21775=DBVPG 6264=IFO 1687=LY 1321
Source:D.Yarrow,CBS,Delft,The Netherlands
Isolated from(substrate):IN,insect larvae on fruit tree
Substrate location:Rhône,Lyon,France
Genetic info:Robnett PCR#116.1 diff.D1/D2 with Y-11571 and Y-27535.GenBank:D1/D2(U45741)(JQ689044),SSU(AB054280)(JQ698912),EF-1 alpha(JQ699071),RPB1(JQ713055),RPB2(JQ698987).
Growth media:Yeast Extract-Malt Extract-Peptone-Glucose(YM for yeasts)(number 6)
Optimum growth temperature:25C
Strain images:
NRRL_Y-7124_6.JPG
 Comments:type strain of Pichia stipitis
Comments:type strain of Pichia stipitis